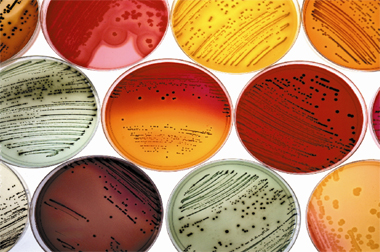

محیط کشت ای کوالی براث |محیط کشت E.Coli Broth |محیط کشت EC Broth
محیط EC براث توسط Hajna و Perry طراحی شده و برای بررسی آب، شیر و سایر مواد برای نشان دادن آلودگی مدفوعی استفاده می شد.
محیط کشت اوره آگار بیس | محیط کشت Urea Agar Base
اوره آگار یک محیط افتراقی برای شناسایی اعضای انتروباکتریاسه بر اساس توانایی آن ها در داشتن آنزیم اوره آز و تجزیه اوره، می باشد.
محیط کشت XLD آگار | محیط کشت زایلوز لیزین Deoxycholate آگار
این محیط توسط تیلور به منظور افزایش بهره وری جداسازی و شناسایی گونه های پاتوژن به ویژه شیگلا می باشد.
محیط کشت اس اس آگار | محیط کشت SS Agar
یک محیط انتخابی و افتراقی برای جداسازی باسیل های پاتوژن به ویژه آنهایی که متعلق به جنس سالمونلا هستند، می باشد.
محیط کشت تریپتون واتر | محیط کشت Tryptone water
تریبپتون واتر برای تشخیص اشریشیاکلی در نمونه های غذا و آب بر اساس تولید ایندول، توصیه می شود. ممکن است برای تمایز باکتری ها از هم بر اساس تولید ایندول نیز استفاده شود.
محیط کشت بروسلا آگار | محیط کشت Brucella Agar
بروسلا آگار یک محیط کشت برای کشت ارگانیسم های بروسلا است که با افزودن 5% خون اسب، این محیط برای روش های کیفی جداسازی و کشت میکرو ارگانیسم های سخت رشد و غیر سخت رشد از نمونه های بالینی و غیر بالینی کاربرد پیدا می کند.
محیط کشت بلاد آگار بیس | محیط کشت Blood Agar Base
این محیط برای جداسازی، کشت و تشخیص فعالیت های همولیتیک استرپتوکوک ها و سایر میکرو ارگانیسم ها مورد استفاده قرار می گیرد.
محیط کشت Simons Citrate Agar | محیط کشت سیمون سیترات آگار
این محیط برای تمایز باکتری های گرم منفی بر اساس استفاده از سیترات است.
محیط کشت Potato Dextrose Agar | محیط کشت پوتیتو دکستروز آگار
این محیط کشت برای کشت و شمارش مخمرها و کپک ها استفاده می شود.
محیط کشت اس آی ام مدیوم | محیط کشت SIM مدیوم | محیط کشت SIM Medium
این محیط برای جداسازی باسیل های روده ای بر اساس تولید سولفید، تشکیل ابندول و تحرک استفاده می شود.
محیط کشت پلیت کانت آگار | محیط کشت Plate Count Agar
فرمولاسیون این محیط کشت مطابق با تعریف متدهای استانداردهای آزمون محصولات لبنی می باشد.
محیط کشت جی سی آگار بیس | محیط کشت GC Agar Base
این محیط با افزودن انواع مختلفی از مکمل ها برای شناسایی و کشت Neisseria gonorrhoeae و دیگر میکرو ارگانیسم های سخت رشد استفاده می شود.
محیط کشت ال بی براث | محیط کشت LB Broth
این محیط یک محیط غنی از مواد غذایی برای رشد، نگه داری و کشت سویه های جدید و نوترکیب اشریشیاکلی استفاده می شود.
محیط کشت کینگ بی آگار | محیط کشت King B Agar
نام دیگر این محیط Pseudomonas Agar F یا Flo Agar است که برای تولید بیشتر ماده فلورسین در گروه سودوموناس به کار می رود.
محیط کشت مکانکی آگار | محیط کشت MacConkey agar
این محیط برای جداسازی باکتری های تخمیر کننده لاکتوز از غیر تخمیر کننده ها به کار می رود.
محیط کشت مالت اکسترکت آگار | محیط کشت Malt Extract Agar
این محیط کشت برای جداسازی، کشت و شمارش مخمر ها و کپک ها به کار می رود.
محیط کشت ام آر اس آگار | محیط کشت MRS Agar
این محیط برای جدا سازی، شمارش و کشت از گونه های لاکتو باسیلوس به کار می رود.
محیط کشت مولر هینتون آگار | محیط کشت Mueller Hinton Agar
کاربرد اصلی محیط مولر هینتون آگار جهت تعیین حساسیت آنتی بیوتیکی باکتری ها (آنتی بیوگرام) به روش دیسک می باشد.
محیط کشت نیترات براث| محیط کشت Nitrate Broth
نیترات براث به عنوان کمک در شناسایی میکرو ارگانیسم های هوازی و بی هوازی گرم منفی با استفاده از آزمون کاهش نیترات، توصیه می شود.
محیط کشت نوترینت آگار | محیط کشت Nutrient Agar
محیط کشت نوترینت آگار برای کشت باکتری ها و شمارش میکرو ارگانیسم ها در آب، فاضلاب، مدفوع و سایر مواد دیگر استفاده می شود.
- 1
- 2
شرکت اوج آزما پلاست در سال 1392 در ایران تاسیس گردید. هدف اصلی همکاران ما کوشش در جهت بالابردن سطح سلامت در جامعه جهانی است. شرکت اوج آزما پلاست در زمینه واردات و تولیدات تجهیزات و ملزومات آزمایشگاهی و بیمارستانی فعالیت داشته و از ابتدای شروع فعالیت همواره
شرکت اوج آزما پلاست در سال 1392 در ایران تاسیس گردید. هدف اصلی همکاران ما کوشش در جهت بالابردن سطح سلامت در جامعه جهانی است. شرکت اوج آزما پلاست در زمینه واردات و تولیدات تجهیزات و ملزومات آزمایشگاهی و بیمارستانی فعالیت داشته و از ابتدای شروع فعالیت همواره